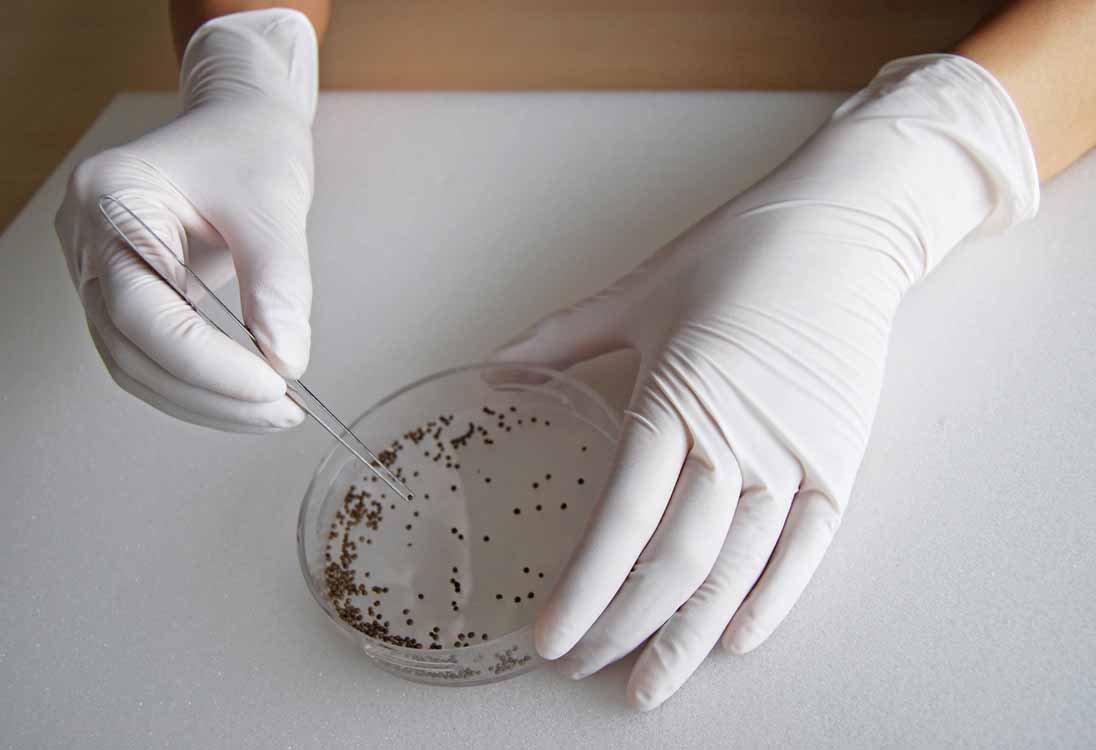

Item Descriptions:
size:
● Easy to take out Box type nitrile rubber made use gloves 100 pieces.
● You can use it even in direct contact with foods such as food processing.
● It conforms to the standards of foods, additives etc. according to the Food Sanitation Law (Notice No. 370 of Ministry of Health and Welfare in 1954).
● In order to make it easier to get rid of, we are applying inner treatment.
● Ultra thin type that can make use of bare hand feeling.
● Because it is made of nitrile rubber, it is excellent in oil resistance.
● Because it has elasticity and softly fits your hands, it is also suitable for long working hours.
● It is thin and suitable for hands, so it is suitable for fine work.
● It is a dual-purpose type.
● It is a powder free type.
Features:
Product information:
Shipping Weight: 589 g
Package Dimensions: 8.00 x 11.91 x 24.10 cm
SHIPPING METHOD
Delivered directly from Japan by Japan Post. It will take 3 to 5 business days to prepare the order for shipping. We guarantee careful packing and safe shipping.Please note that in some cases additional import or VAT charges may incur and have to be borne by the client.
1. Japanpost registered mail
Shipment by Japanpost Registered Mail (Standard). Trackable any time with tracking number. Insurance is not available. Delivery time usually is between 1-3 weeks from the date of dispatch. Some items are not eligible for Standard Shipping.
2. Qxpress Standard
Shipment by Qxpress standard service. Trackable at any time with tracking number. Registered and insured up to a value of item price and shipping fees.Delivery time is usually between 5-10 business days from the date of dispatch.
3. EMS
Shipment by Expedited Mail Service. Trackable at any time with tracking number. Registered and insured up to a value of $200 and usually delivered in 2-6 business day from the date of dispatch.

| Japanpost registered mail | Qexpress | EMS | |
|---|---|---|---|
| Shipping Method | Japanpost Registered Mail (Standard) | Standard Qexpress | EMS (Expedited Mail Service) |
| Trackable | Yes | Yes | Yes |
| Insured | N/A | Yes (Up to item price and shipping fees) | Yes (Up to $200.00) |
| Asia | 1-3 weeks | 5-10 days | 2-5 days |
| Oceania; North America; Central America and the Middle East | 2-4 weeks | 6-14 days | 2-6 days |
| Europe | 2-4 weeks | 6-16 days | 3-8 days |
| South America and Africa | 2-4 weeks | 10-18 days | 4-8 days |
NOTICE:
"According to Qoo10 guide line,overseas shipping fees will be charged to you extra if you choose Qxpress standard shipping.We recommend you to compare the total price of your purchase with EMS."
